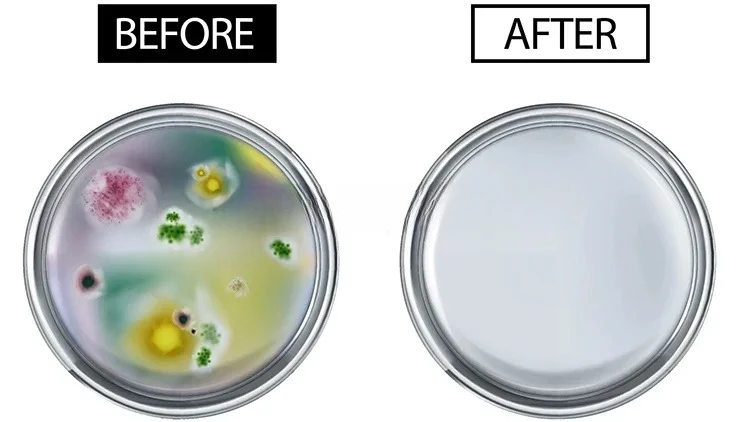
Hot Selling Mushroom Autoclave 150L Product Good Price Hospital Disinfection Equipment Sterilization Disinfection Equipment

1 комплект, бюстгальтер, трусики, костюм с ремнем на талии, цветочная вышивка, прозрачная сетка, чувственные стринги, тонкие соблазнительные регулируемые трусики с высокой талией, нижнее белье, костюм

артикул: 66150f7a1f8fb701fa9d5a46
СОГЛАСНО НАШИМ ДАННЫМ, ЭТОТ ПРОДУКТ СЕЙЧАС НЕ ДОСТУПЕН
1,350.00 руб.
Доставка из: Россия
График изменения цены & курс обмена валют
Пользователи также просматривали

447.94 руб.
Strainer Anti-blocking Black Roof Drain Outdoor Downpipe Home Filter Leaves Protection Easy Install Gutter Guard PP Debris
aliexpress.com
2,065.57 руб.
Engine Case Saver Prevent Broken Mounts Chain Guard Kits Fit for Yamaha Raptor 700 YFM700 700R YFM700R New High Quality
aliexpress.com
2,034.97 руб.
Fluororubber Watch Strap For OMEGA SEAMASTER 300/600 21mm Soft Black Green Blue Orange rubber Men's Sport Watchband
aliexpress.com
30,954.46 руб.
Электрический камин Вставка Ретро Встраиваемый обогреватель Встреча огня Звук Дистанционное управление Таймер 750/1500 Вт Стиль кирпичной стены Черный.
aliexpress.ru
90,216.52 руб.
USA patent hard tri fold tonneau truck bed cover for GMC SIEERA CHEVY SILVERADO
aliexpress.com
1,998.10 руб.
2Pcs Xenon HID D1S Headlights 35W Car Bulb For MERCEDES-BENZ G CLASS W463 2000 2001 2002 2003 2004 2005 2006 2007 2008 2009 2012
aliexpress.com
143.56 руб.
Мини-скутер из сплава, детская игрушка, двухколесный скутер, детские развивающие игрушки
aliexpress.ru
608.77 руб.
Тренировочные Сумки на шнурке для собак, рюкзак, персонализированная сумка на шнурке для ежедневного подарка, несколько стилей
aliexpress.ru
123.17 руб.
2 шт. острый Резак Режущий инструмент для художественного ремесла для наклеек «сделай сам» нож Замена микро-лезвия ремесленный нож
aliexpress.ru
299.68 руб.
Регулируемая крепкая присоска держатель для душевой лейки подставка с поворотом на 360 градусов
aliexpress.ru
5,817.00 руб.
Новинка 2023, качественное женское сексуальное Белое платье средней длины без бретелек с перьями, роскошное вечернее платье
aliexpress.ru
24,127.03 руб.
Подушка эргономичный офисный стул, спинка, скользящие спальни, мобильные офисные стулья, Удобная белая симпатичная мебель
aliexpress.ru
1,037.88 руб.
Женская шелковая Солнцезащитная одежда, тонкая летняя воздухопроницаемая модная одежда в Корейском стиле для защиты от солнца, новинка 2023
aliexpress.ru
903.73 руб.
Умный датчик утечки воды Tuya Smart Zigbee 3,0, бытовой перелив, бытовая автоматизация, работа с Alexa Home
aliexpress.ru
800.18 руб.
Женское модное платье без бретелек, облегающее платье средней длины с принтом, привлекательное летнее женское платье с открытой спиной
aliexpress.ru
1,422.28 руб.
Baofeng BF S99 BFS99 Walkie Talkie 8W High Power Handheld Two Way Ham CB Radio FM Transceiver Update 888S Intercom 10KM 10 50 KM
aliexpress.com
1,445.03 руб.
Handled Digital LED Shower Head Shower Head Pressurized Colorful Handheld Water - Saving Powered Spray for Baby Pregnant Women
aliexpress.com
1,030.04 руб.
A5 Hardcover Elastic Bandage Dotted Notebook Journal School Diary Notebook Stationery Supplies 128 Sheets Thick Bullet Journal
aliexpress.com
1,843.55 руб.
10.1" 1280*800 40Pin display for Digma Plane 10.3 3G PS1043MG lcd Screen replacement
aliexpress.com
2,014.51 руб.
new fashion 4358 sunglasses women's sun and uv protection men's glasses, White;black
dhgate.com
2,192.65 руб.
hair clips & barrettes white floral comb bridal piece gold silver color leaf wedding headpiece rhinestone women jewelry, Golden;silver
dhgate.com
503.64 руб.
Amoliy 7 шт. большой размер русская выпечка обледенение трубопроводов фонарь сопла из нержавеющей стали украшения наконечник торт кекс аксесс...
aliexpress.ru
804.89 руб.
Папка для бумаг формата A6 с системой конвертов наличными, бюджетные листы, стикеры с разными категориями, для бюджетных и экономных денег
aliexpress.ru
1,777.66 руб.
2022 New Smart Watch Men Custom Dial Heart Rate Blood Oxygen Monitor Sport Watches Women IP67 Waterproof Smartwatch For Swimming
aliexpress.com
1,558.78 руб.
Projector Lamp, Night Light Star Projector, Galaxy Planets Projector Light 15 Colors Nebula Starlight Projector Light
aliexpress.com
866.08 руб.
Women Sexy Bikinis Set Solid Color Hollow Out One Shoulder Bikini Push Up Bra G-string Briefs Summer Women's Swimwear
aliexpress.com
48,185.03 руб.
fat reducing body slimming machine for skin care hifu body slimming convenient portable slim equipment
dhgate.com
16,049.13 руб.
car oem front bumper fog light lamp set with wiring & switch for ford ranger 2015-2018
dhgate.com
2,066.35 руб.
women's slim jacket buttons casual all-match suit jacket slim short lapel women's winter mature temperament small suit, White;black
dhgate.com
599.35 руб.
women designer clothes lips print long-sleeved t shirt shorts two pieces outfits home wear plus size fashion casual sport suits f112503, White
dhgate.com6,151.20 руб.
55cm Silicone cute Reborn Baby Doll Toy like Real 22'' Soft Vinyl Newborn reborn modeling Girl Bonecas kids birthday gifts
aliexpress.com
48.41 руб.
10PCS чехол Huawei Р30 Р20 Lite Pro Р10 плюс Р9 Р8 SMART 2019 покрыты тонким силикагелем
dhgate.com
3,706.72 руб.
LIGE Mens Watches Top Brand Luxury Stainless Steel Quartz Clock Chronograph Business Waterproof Date Watch Man Relogio Masculin
aliexpress.com
132.58 руб.
36172-P08-015 For Honda Civic solenoid valve gasket Applicable 36172-P08-005
aliexpress.com
109.83 руб.
4 Pcs Braiding Tool Large Banana Hair Clips for Women Accessories Braids Care Product
aliexpress.com
393.03 руб.
1 шт., подвески для обуви из ПВХ для крокодилов, аксессуары, значок авокадо, женские сандалии с пряжкой, детские булавки, мужские украшения, джинсы, рождественский подарок
aliexpress.ru
80.80 руб.
Golden Hat Pickup Selector for Bass Aluminum Alloy 5 Way with Tip Guitar Switch
aliexpress.com
166,473.00 руб.
Hot Selling Mushroom Autoclave 150L Product Good Price Hospital Disinfection Equipment Sterilization Disinfection Equipment
aliexpress.com
333.41 руб.
8 Pcs White Thin Storage Bins Rectangle Box Office Bathroom Under Sink Organizer Pantry Closet Shelf Solution Multifunctional
aliexpress.com





